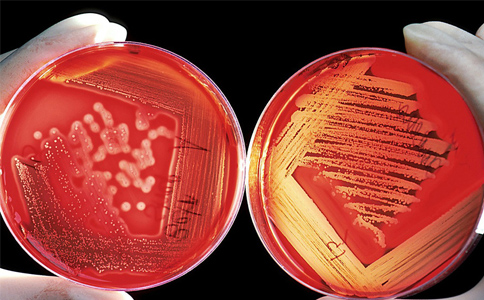
跨学科研究

随着人类思维的进步和科学技术的发展,人类社会面临的各种问题也日益复杂化。因此,我们有必要打破各学科之间的信息孤岛,与来自相近学科领域、甚至是完全不同领域的研究伙伴合作,解决各种问题。查尔斯沃思论文润色将在本文讨论如何开展跨学科合作,以及跨学科合作需要注意哪些问题,研究人员应该具备哪些技能(尤其是软技能)。
1.互相分享自己学科的专业知识
需要时刻注意的是,你的合作者可能来自不同的研究领域。这意味着与你合作的可能是个精通某领域的国际专家,但是这个领域可能与你擅长的研究领域大相径庭。因此,在多学科研究项目中,与合作者分享所在学科与项目有关的专业知识,有利于推动富有成效的合作。
2.以通俗易懂的语言交流
在讨论彼此的研究领域和一般交流的过程中,最好使用通俗易懂的语言与合作者进行有效沟通,仅在必要时使用术语。你应该对项目的最终目标了然于心,而不应拘泥于研究过程中出现的细枝末节。这有助于克服潜在的语言障碍,因为合作者可能来自不同国家和文化背景。同时也有利于加强与普罗大众进行有效沟通的技能,因为他们对你的研究领域知之甚少,不如你精通。
3.拓宽视野,不钻牛角尖
开展一项多学科研究项目通常是为了解决范畴更广的问题,例如考究某个医学现象带来的社会影响,或者某项制造工艺的变化对相关生物制品的影响等等。因此,比较有用的方法是保持思维开阔,把视野拓展到本专业以外的领域。
思维开阔有助于研究推进,因为思维开阔代表着更丰富的经验,可以帮你脱离本专业的特定视角,以更广阔的视野来考虑问题,促使你对所在领域进行创造性思考,打开对后续研究和研究方法的创新思路。
4.保持开放的心态
在进行多学科研究工作时,最重要的一点,就是来自不同背景和领域的研究人员齐聚一堂共同开展研究,他们作为相关领域的代表推动研究取得成功。因此,要乐于听取和接受其他研究领域的观点,并确保自己的研究目标与总体研究目标保持一致,这一点至关重要。
小 结
随着多学科研究的日渐普遍,成功的科研合作更加需要良好的沟通和团队协作技能。而对科研人员来说,亟需掌握这些技能。归根结底,就是要想方设法力求清晰地传达你的专业知识,便于他人理解和合作,同时对新思路持开放态度。